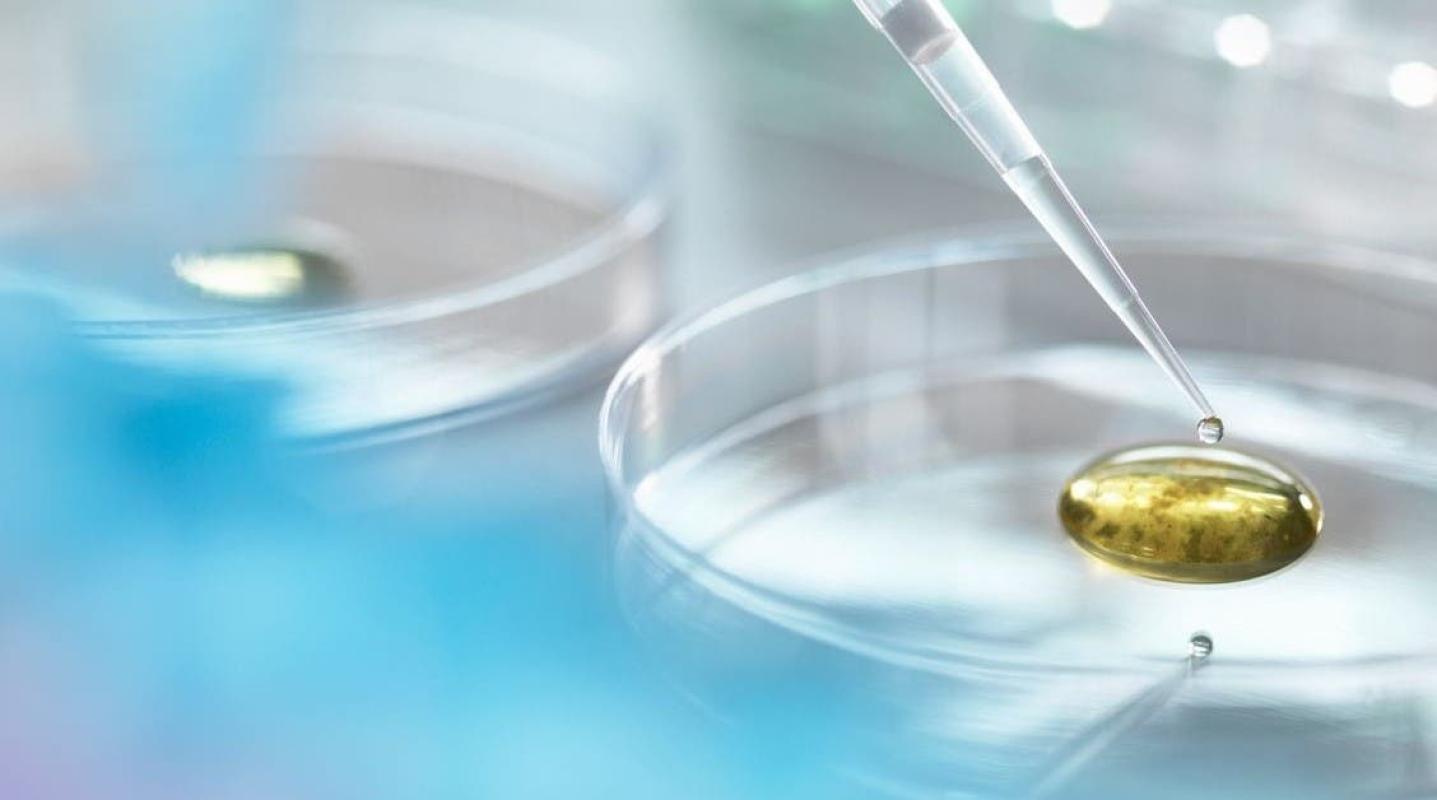

Más de 3 mil personas se enfermaron tras la fuga de una bacteria desde un laboratorio en China
Más de 3 mil personas se enfermaron tras la fuga de una bacteria desde un laboratorio en China
Más de 3 mil personas se enfermaron tras la fuga de una bacteria desde un laboratorio en China
T13 En Vivo
Más de 3.000 personas en el noroeste de China se enfermaron después de que en 2019 se escapara una bacteria de una planta biofarmacéutica que produce vacunas para animales, dijeron las autoridades.
La brucelosis es una enfermedad transmitida por el ganado o los productos animales. Generalmente no es contagiosa entre los humanos pero puede provocar fiebres, dolor en las articulaciones y dolores de cabeza.
Un total de 3.245 personas dieron positivo en las pruebas a esta bacteria, una cifra establecida tras los análisis realizados desde el incidente, según las autoridades sanitarias de Lanzhou, la capital de la provincia de Gansu, que indicaron que no se ha producido ninguna transmisión de humano a humano.
Un laboratorio estatal de la ciudad usó un desinfectante caducado en julio y agosto de 2019 en la producción de vacunas contra la brucelosis para animales, dijeron las autoridades el martes.
Como resultado, la esterilización fue incompleta y las bacterias todavía estaban presentes en las emisiones de gas de la compañía, la planta biofarmacéutica de Lanzhou para cría de animales.
El gas contaminado se propagó por el aire hasta el cercano Instituto de Investigación Veterinaria, donde infectó a casi 200 personas en diciembre pasado.
La Oficina de Salud de Lanzhou dijo el viernes que la bacteria suele proceder de ovejas, vacas o cerdos.
El laboratorio se había disculpado este año y se le había revocado la licencia para producir vacunas contra la brucelosis.
Los pacientes recibirán una compensación económica a partir de octubre, según las autoridades de Lanzhou.









